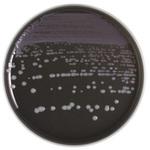

マイストア
変更
お店で受け取る
(送料無料)
配送する
納期目安:
2025.09.25 1:37頃のお届け予定です。
決済方法が、クレジット、代金引換の場合に限ります。その他の決済方法の場合はこちらをご確認ください。
※土・日・祝日の注文の場合や在庫状況によって、商品のお届けにお時間をいただく場合がございます。
【専用】ペーま 様 タジマ TAJIMA TJMデザイン セフコンベZ 2 マグ爪25 5.5mの詳細情報
タジマ TAJIMA TJMデザイン セフコンベZ 2 マグ爪25 5.5m。BE@RBRICK 達磨 フィギュア ペコちゃん 金メッキ 100% & 400。252164 BD BBL TM BCYE寒天培地 20枚 1個(20枚×1本) ベクトン。アキュレート™ XM-カンジダ寒天培地 | 臨床診断薬分野 医療関係。
商品説明
専用ページです
商品情報
ベストセラーランキングです
近くの売り場の商品
カスタマーレビュー
オススメ度 4.3点
現在、4813件のレビューが投稿されています。

![その他 Winners & Boozers [CD]](https://img.fril.jp/img/760374172/l/2568128864.jpg)